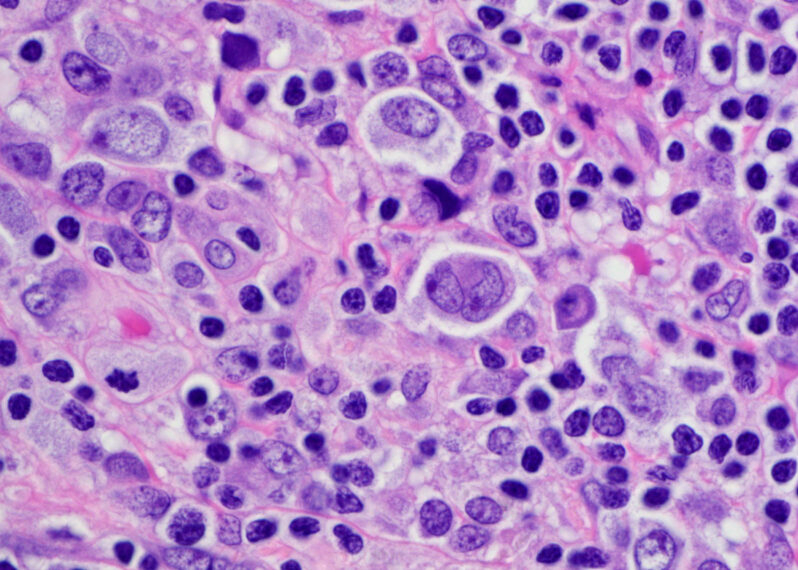

Market Overview:
Anatomic pathology focuses on the diagnosis of disease through macroscopic, microscopic, biochemical, immunological and molecular examination of organs and tissues. Anatomic pathology services help clinicians diagnose diseases and determine appropriate treatment plans. Advanced techniques such as immunohistochemistry, molecular pathology, flow cytometry and cytogenetics are commonly used in anatomic pathology to identify disease at the molecular level. With the increasing trend of personalized medicine, anatomic pathology plays a vital role in disease diagnosis and targeted treatment.
Market key trends:
One of the key trends in the anatomic pathology market is the growing adoption of digital pathology. Digital pathology utilizes computer technologies like whole slide imaging to convert glass slides into high-resolution digital slides that can be viewed, managed and shared on a computer screen. Compared to traditional glass slides, digital pathology offers benefits like remote viewing, easy sharing, integration with laboratory systems and data analytics. Many prominent players are introducing digital pathology solutions equipped with AI and machine learning capabilities for advanced disease diagnosis. For example, Philips offers IntelliSite Pathology Solution that uses AI-based algorithms to assist pathologists. Rising demand for advanced diagnostics is expected to propel the digital pathology market over the forecast period.
The global Anatomic Pathology Market Growth is estimated to be valued at US$ 30.16 Bn in 2023 and is expected to exhibit a CAGR of 8.7% over the forecast period 2023-2030, as highlighted in a new report published by Coherent Market Insights.
Porter’s Analysis
Threat of new entrants: The anatomic pathology market requires significant investments in technology, infrastructure and skilled workforce which acts as a barrier for new entrants.
Bargaining power of buyers: Individual consumers have low bargaining power due to specialized diagnostic services whereas large hospitals and clinics can negotiate better pricing.
Bargaining power of suppliers: Suppliers of diagnostic instruments and equipment have moderate bargaining power due to the availability of substitution but proprietary technologies provide some differentiation.
Threat of new substitutes: Threat of substitutes is low as anatomic pathology diagnostic tests have well-established clinical guidelines and switching involves high validation costs.
Competitive rivalry: The anatomic pathology market is highly competitive with major players competing on technology, portfolio expansion and geographic presence.
Key Takeaways
The global anatomic pathology market is expected to witness high growth, exhibiting CAGR of 8.7% over the forecast period, due to the increasing prevalence of chronic diseases and cancer coupled with the rising geriatric population.
Regional analysis: North America dominates the anatomic pathology market currently owing to presence of major players, increasing healthcare expenditure and faster adoption of advanced technologies. Asia Pacific is expected to witness highest growth rate due to growing medical tourism, rising healthcare expenditure and increasing focus of key players in developing countries.
Key players: Key players operating in the anatomic pathology market are Danaher PHC Holdings CorporationQuest Diagnostics IncorporatedLaboratory Corporation of America HoldingsF. Hoffmann-La Roche AGAgilent Technologies, Inc.Cardinal HealthSakura Finetek USA, Inc.NeoGenomics Laboratories, Inc.BioGenexBio SB. These players are focusing on new product launches, strategic partnerships and geographic expansion to strengthen their market position.
*Note:
1. Source: Coherent Market Insights, Public sources, Desk research
2. We have leveraged AI tools to mine information and compile it